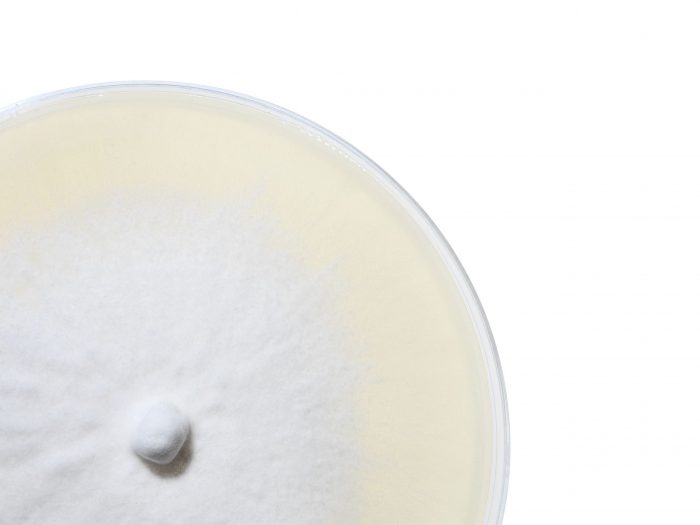
Plain Acoustic Panels - Image 8

Plain Acoustic Panels
Acoustic collection marks an unprecedented revolution for interior design comfort.
Acoustic modules are made from soft, foam like mycelium materials grown on upcycled textile residues. Thanks to the unique technology, Acoustic panels represent today the most sustainable solution dedicated to acoustic comfort. They are characterised by a unique velvety finishing and different 3D shape, to maximise sound absorption as well as aesthetic comfort.
PLAIN: Less is more. Sometimes simple volumes valorise the unique qualities of a material better than any complex shape. The Plain modules are regular flat tiles allowing for interesting and playful compositions, while shouting their manifesto through a silent simplicity. Relaxing at home or busy at work, comfort is always paramount. The Plain model is available as square or rectangle shaped tiles and in different sizes, allowing for different typologies of compositions and arrangements.
Non-GMO, non-allergenic fungal strains, which do not release any spores throughout the whole production process. The materials have been tested for allergenic and VOC Emissions.
Available in the natural white version as well as in a range of colours, please refer to colour sheet attached below.
| Acoustic Properties | 0.4 |
|---|---|
| UV Resistance | Excellent |
| Colour | Natural White |
| Dimensions | Plain 100: 50x100x4 cm, 1.5 kg, Plain 50: L50xW50xH4 cm, 1 kg, Plain 60: L60xW60xH4 cm, 1.2 kg |
| Density | 180 kg/m3 |
| Fire Reaction | B-s2-d0 |
| Made in | Italy |
| Use | Indoor, Wall |
| Sustainability | Low VOC, Natural Materials |